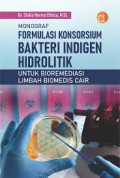
cover

Rempah-Rempah dan Essential Oil: Sebagai Antibakteri dan Antioksidan Hidrogel…
Buku ini mengulas tentang sifat antibakteri, karakteristik kimia, serta sifat-sifat mekanis dari hidrogel yang dengan bahan dasar polivinil alkohol dan hidrokoloid dari polisakarida alami, seperti …
- Edisi
- -
- ISBN/ISSN
- 978-623-02-9078-7
- Deskripsi Fisik
- xii, 77 hlm
- Judul Seri
- -
- No. Panggil
- 581.634 SAR r

Elektrokimia Dalam Pemisahan dan Deteksi Senyawa Organik Beracun
Buku yang berjudul Elektrokimia Dalam Pemisahan Dan Deteksi Senyawa Organik Beracun merupakan karya dari Prof. Dr. Rahadian Zainul, S.Pd., M.Si. Dalam Buku ini dibahas terkait berbagai pembahasan t…
- Edisi
- -
- ISBN/ISSN
- 978-623-02-7570-8
- Deskripsi Fisik
- xii, 128 hlm
- Judul Seri
- -
- No. Panggil
- 541.37 ZAI e

Efek Dari Elektrokimia Terhadap Sintesis Dan Karakterisasi Nanopartikel
Buku ini mengajak pembaca untuk dapat mengetahui kemajuan ilmiah dan peningkatan teknologi yang mengacu pada sumber terkini dan peninjauan terbaru oleh para ahli. Mengajak pembaca untuk mendalami t…
- Edisi
- -
- ISBN/ISSN
- 978-623-02-7580-7
- Deskripsi Fisik
- xiv, 156 hlm
- Judul Seri
- -
- No. Panggil
- 541.37 ZAI e

Desain Elektroda Mikrofluida
Elektroda Mikrofluida membahas berbagai aspek penting terkait mikrofluida, mulai dari pendahuluan yang mencakup dasar-dasar mikrofluida, hingga desain mikrofluida biosensor yang inovatif. Melalui b…
- Edisi
- -
- ISBN/ISSN
- 978-623-02-8272-0
- Deskripsi Fisik
- xx, 122 hlm
- Judul Seri
- -
- No. Panggil
- 333.9539 ZAI d

Kimia Dasar Mahasiswa Milenial
Buku Kimia Dasar Mahasiswa Milenial Salah satu implementasi kampus merdeka adalah referensi yang menunjang merdeka belajar. Buku Kimia Dasar ini menyajikan konsep-konsep dasar ilmu kimia yang dibah…
- Edisi
- -
- ISBN/ISSN
- 978-623-02-4905-1
- Deskripsi Fisik
- viii, 193 hlm
- Judul Seri
- -
- No. Panggil
- 540.1 SUJ k

Higher-Order Thinking Skills: Kimia Dalam Materi Larutan dan Socioscientific …
Larutan dan Socioscientific Issues Buku Higher-Order Thinking Skills: Kimia dalam Materi Larutan dan Socioscientific Issues Buku Kimia ini yang berjudul Buku Higher-Order Thinking Skills: Kimia dal…
- Edisi
- -
- ISBN/ISSN
- 978-623-02-8818-0
- Deskripsi Fisik
- x, 141 hlm
- Judul Seri
- -
- No. Panggil
- 370.152 RAH h

Elektrokimia Dalam Analisis dan Pemisahan Biomolekul
Buku Elektrokimia yang berjudul Elektrokimia dalam Analisis dan Pemisahan Biomolekul merupakan karya dari Prof. Dr. Rahardian Zainul, S.Pd., M.Si.Metode elektrokimia telah mendapatkan perhatian yan…
- Edisi
- -
- ISBN/ISSN
- 978-623-02-7507-4
- Deskripsi Fisik
- xii, 137 hlm
- Judul Seri
- -
- No. Panggil
- 541.37 ZAI e

Inovasi Model-Model Pembelajaran dan Penerapannya dalam Pembelajaran Kimia
Penerapannya dalam Pembelajaran Kimia Buku Inovasi Model-Model Pembelajaran dan Penerapannya dalam Pembelajaran Kimia Buku Pendidikan Kimia ini yang berjudul Buku Inovasi Model-Model Pembelajaran d…
- Edisi
- -
- ISBN/ISSN
- 978-623-02-8986-6
- Deskripsi Fisik
- x, 105 hlm
- Judul Seri
- -
- No. Panggil
- 540.7 SUG i

Nanokimia Anorganik Memperkuat Pewarnaan Alam
uku ini menjelaskan bagaimana hidup dan kehidupan dapat menjadi lebih indah dan bermakna melalui pewarnaan alam. Pembahasannya dimulai dengan menggarisbawahi pentingnya pewarna alam sebagai alterna…
- Edisi
- -
- ISBN/ISSN
- 978-623-02-8424-3
- Deskripsi Fisik
- xiv, 133 hlm
- Judul Seri
- -
- No. Panggil
- 701.85 KAR n

Mengenal Teknik Laboratorium Kimia Organik
Buku Mengenal Teknik Laboratorium Kimia Organik Penguasaan pengetahuan dan keterampilan sangat penting sebelum memulai bekerja di laboratorium kimia. Laboratorium di masing-masing bidang kimia memi…
- Edisi
- -
- ISBN/ISSN
- 978-623-02-5938-8
- Deskripsi Fisik
- vi, 188 hlm
- Judul Seri
- -
- No. Panggil
- 547 SOE m

Karya Umum
Karya Umum  Filsafat
Filsafat  Agama
Agama  Ilmu-ilmu Sosial
Ilmu-ilmu Sosial  Bahasa
Bahasa  Ilmu-ilmu Murni
Ilmu-ilmu Murni  Ilmu-ilmu Terapan
Ilmu-ilmu Terapan  Kesenian, Hiburan, dan Olahraga
Kesenian, Hiburan, dan Olahraga  Kesusastraan
Kesusastraan  Geografi dan Sejarah
Geografi dan Sejarah